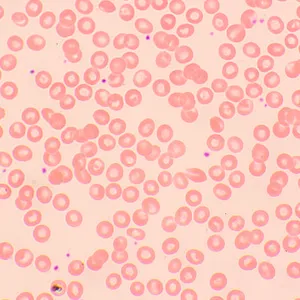
Микроскоп биологический MAGUS Bio 250TL, изображение 22

Микроскоп биологический MAGUS Bio 250TL
Увеличение: 40–1000 крат. Тринокулярная визуальная насадка, объективы-планахроматы, светодиодный осветитель 3 Вт

| Артикул | 82891 | |
| Страна | КНР для ПАО «Левенгук» (Россия) | |
| Бренд | MAGUS (Магус) | |
| Гарантия | 5 лет | |
| Размер упаковки (ДxШxВ) | 43x27x63 см | |
| Вес в упаковке | 10.5 кг |
С помощью микроскопа MAGUS Bio 250TL изучают тонкие срезы и мазки биологических образцов. Исследования ведутся в светлом поле в проходящем свете. В качестве осветителя выступает 3-ваттный светодиод, а оптика включает планахроматические объективы, рассчитанные на бесконечность. Микроскоп поддерживает установку дополнительных аксессуаров, в том числе устройств для работы по методам темного поля, поляризованного света и фазового контраста. Этот микроскоп – идеальный выбор для лабораторной диагностики, научных исследований и обучения.
Оптика
Тринокулярная насадка состоит из двух окулярных тубусов для визуальных наблюдений и вертикального канала визуализации, в который устанавливается цифровая камера (нет в комплекте). Тубусы имеют удобный для длительной работы наклон в 30° и могут вращаться на 360° для настройки высоты выноса зрачка под рост наблюдателя. Присутствует и диоптрийная подвижка – кольцо расположено на левом тубусе.
Объективы устанавливаются в 5-гнездное револьверное устройство: в комплектацию включено 4 объектива, поэтому одно гнездо остается свободным. В него можно установить любой дополнительный объектив, благодаря чему внутри диапазона кратности будет доступно еще одно увеличение. Во время работы введенный в ход лучей объектив хорошо виден, так как револьверное устройство повернуто «от наблюдателя». Это же освобождает пространство над предметным столиком.
Наблюдения ведутся в диапазоне от 40 до 1000 крат, но это касается только базовой комплектации. Если дополнить ее опциональными окулярами, верхний предел увеличения повысится.
Освещение
Светодиод, установленный в нижней части микроскопа, ярко и равномерно освещает объект. Цветовая температура остается постоянной при смене яркости. Мощность осветителя составляет 3 Вт. Ресурс работы – 50 000 часов. Для питания используется подключение к сети переменного тока.
При помощи регулировки положения конденсора Аббе и открытия или закрытия апертурной и полевой диафрагм можно настраивать освещение по методу Кёлера. Для работы по методам темного поля и фазового контраста можно использоваться слайдеры, для установки которых в конденсоре предусмотрен специальный слот. При помощи слайдера смена метода исследования происходит очень быстро.
Механика
Выдвижной рейки у предметного столика нет, значит, во время работы она не будет мешать, а сам микроскоп займет меньше места на рабочем столе. Препаратоводитель, который перемещает образец, снимается – это полезно, если планируется ручное сканирование.
Для наводки на резкость применяются грубая и тонкая фокусировки – рукоятки расположены с двух сторон корпуса. Так как они находятся ближе к основанию, руки во время работы не нужно держать на весу, а можно свободно положить на стол. Жесткость хода грубой фокусировки можно настроить в соответствии со своими нуждами, также есть блокиратор хода грубой фокусировки. Фокус настраивается плавно и без усилий.
Аксессуары
Возможности микроскопа MAGUS Bio 250TL могут быть расширены благодаря линейке аксессуаров, в которую входят окуляры, объективы, калибровочные слайды, цифровые камеры, устройства для работы в темном поле, поляризованном свете, с использованием фазового контраста.
Основные особенности:
- Тринокулярная визуальная насадка, револьвер на 5 объективов, планахроматическая оптика с расчетом на бесконечность
- Окулярные тубусы вращаются на 360° для удобной настройки высоты взора под рост наблюдателя
- На левом тубусе есть диоптрийная подвижка, предусмотрена грубая и тонкая фокусировки
- Для грубой фокусировки существуют механизм блокировки и механизм регулировки жесткости хода
- Конденсор Аббе центрируется и регулируется по высоте, наличие полевой и апертурной диафрагм позволяет настраивать освещение по Кёлеру
- Источник проходящего света – 3-ваттный светодиод регулируемой яркости, питание осуществляется от сети 220 В
- Возможность установки опциональных аксессуаров
Комплектация:
- Штатив со встроенным источником электропитания, источником проходящего света, механизмом фокусировки, предметным столиком, кронштейном конденсора и револьвером объективов
- Конденсор Аббе
- Тринокулярная визуальная насадка
- Объектив-планахромат, рассчитанный на бесконечность: 4x/0,10
- Объектив-планахромат, рассчитанный на бесконечность: 10x/0,25
- Объектив-планахромат, рассчитанный на бесконечность: 40x/0,65 (подпружиненный)
- Объектив-планахромат, рассчитанный на бесконечность: 100x/1,25 ми (подпружиненный)
- Окуляр 10x/22 мм с удаленным зрачком (2 шт.)
- Наглазник на окуляр (2 шт.)
- Светофильтр (4 шт.)
- Переходник под крепление C-mount для работы с камерой
- Флакон с иммерсионным маслом
- Сетевой шнур питания для микроскопа
- Пылезащитный чехол
- Инструкция по эксплуатации и гарантийный талон
Поставляются по дополнительному заказу:
- Окуляр 10х/22 мм со шкалой
- Окуляр 12,5x/14 мм (2 шт.)
- Окуляр 15х/15 мм (2 шт.)
- Окуляр 20х/12 мм (2 шт.)
- Окуляр 25х/9 мм (2 шт.)
- Объектив-планахромат, рассчитанный на бесконечность: 20х/0,40
- Объектив-планахромат, рассчитанный на бесконечность: 60х/0,80 (подпружиненный)
- Фазово-контрастное устройство: фазовый конденсор, набор фазовых объективов, вспомогательный центрирующий телескоп
- Фазово-контрастное устройство: набор фазовых слайдеров, набор фазовых объективов, вспомогательный центрирующий телескоп
- Конденсор темного поля А 0,9
- Конденсор темного поля иммерсионный А 1,36–1,25
- Слайдер темного поля
- Устройство простой поляризации
- Цифровая камера
- Калибровочный слайд
- Монитор
| Артикул | 82891 | |
| Страна | КНР для ПАО «Левенгук» (Россия) | |
| Бренд | MAGUS (Магус) | |
| Гарантия | 5 лет | |
| Размер упаковки (ДxШxВ) | 43x27x63 см | |
| Вес в упаковке | 10.5 кг | |
| Тип | биологические, световые/оптические | |
| Тип насадки | тринокулярная | |
| Насадка | Gemel (Зидентопф с вращением тубусов на 360°) | |
| Угол наклона окулярной насадки | 30° | |
| Диапазон увеличения, крат | 40 — 1000 | |
| Увеличение, крат (опционально) | 40–1200/1250/1500/1600/2000/2500 | |
| Диаметр окулярной трубки, мм | 30 | |
| Окуляры | 10x/22, удаленный зрачок 10 мм (*опция: 10x/22 мм со шкалой, 12,5x/14 мм, 15x/15 мм, 20x/12 мм, 25x/9 мм) | |
| Объективы | планахроматические, скорректированные на бесконечность: 4x/0,10; 10x/0,25; 40xs/0,65; 100xs/1,25 (масляный); парфокальная высота 45 мм (*опция: 20х/0,40; 60хs/0,80) | |
| Револьверное устройство | на 5 объективов | |
| Рабочее расстояние, мм | 21 (4x); 5 (10x); 0,66 (40xs); 0,36 (100xs); 8,8 (20х); 0,46 (60хs) | |
| Межзрачковое расстояние, мм | 48 — 75 | |
| Предметный столик, мм | 180x150 | |
| Диапазон перемещения предметного столика, мм | 75/50 | |
| Характеристики предметного столика | двухкоординатный механический, без выдвижной рейки | |
| Возможность диоптрийной коррекции, D | ±5 (на левом тубусе) | |
| Конденсор | центрируемый и регулируемый по высоте конденсор Аббе NA 1,25 с регулируемой апертурной диафрагмой и слотом для слайдера темного поля и фазового контраста; тип крепления «ласточкин хвост» | |
| Диафрагма | регулируемая апертурная, регулируемая ирисовая полевая | |
| Фокусировка | коаксиальная, грубая (21 мм, 39,8 мм/оборот, с механизмами блокировки и регулировки жесткости) и тонкая (0,002 мм) | |
| Подсветка | светодиодная | |
| Регулировка яркости | ✓ | |
| Источник питания | 220±22 В, 50 Гц, сеть переменного тока | |
| Тип лампы подсветки | светодиод 3 Вт | |
| Светофильтры | есть | |
| Диапазон рабочих температур, °С | 5...+35 | |
| Возможность подключения другого оборудования | фазово-контрастное устройство (конденсор и объективы), конденсор темного поля (сухой или масляный), устройство простой поляризации (поляризатор и анализатор) | |
| Уровень пользователя | для опытных, для профессионалов | |
| Уровень сложности сборки и настройки | сложно | |
| Назначение | лабораторные/медицинские | |
| Расположение подсветки | нижняя | |
| Метод исследования | светлое поле | |
| Чехол/кейс/сумка в комплекте | чехол пылезащитный | |
| Вес, кг | 8 | |
| Габариты, мм | 200x436x400 |